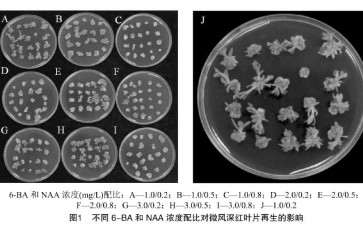
11个盆栽小菊农艺性状观察

盆栽果树怎么栽培管理的技术
12次
11个盆栽小菊农艺性状观察
24次



不同品种微型盆栽月季生根比较试验
37次


不同品种盆栽月季扦插成活率分析
66次


盆栽金桔病虫害怎么防治的2个方法
63次

金桔盆栽怎么整形修剪的3个方法
26次

金桔盆栽怎么浇水的方法 图片
14次

金桔盆栽怎么施肥的方法 图片
16次

盆栽金桔怎么管理的3个方法
43次

盆栽金桔怎么盆土配制的3个方法
96次



盆栽观赏椒怎么植株调整的方法
15次

盆栽观赏椒怎么水肥管理的3个方法
10次